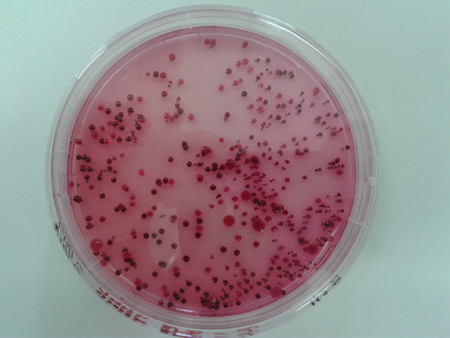

|
След като преобърнаха света нагоре с краката, мистериозните
нанодиаманти са на път да променят из основи бита ни. И да сътворят
чудо в областта на биомедицинските нанотехнологии
Искра
Ценкова
Ако стойността на естествените диаманти зависи от големината им, то
изкуствените нанодиаманти са безценни въпреки микроскопичните им
размери - между два и десет нанометъра. Кристалната им решетка е
като на природните, но формата им е сферична, а не кубична, поради
окъсаните връзки. Въпреки че не можем да ги видим с невъоръжено око,
академиците са убедени, че бъдещето принадлежи точно на тях, както и
на останалите наноматериали, част от които са. Модерното направление
се развива бързо, навлиза във всички области на науката и създава
революционни продукти. За разлика от другите наноматериали тези имат
едно важно предимство – досега няма данни, доказващи тяхната
токсичност. Те са много твърди, влизат в състава на режещите
инструменти. Включени са и в много композитни материали, тъй като
подобряват здравината и свойствата им. Получават се чрез взривен
синтез на свободния въглерод в определен клас взривни вещества, а
добивът им е евтин - от 1 кг смес взривно вещество се получават
около 45-50 г нанодиаманти. В характеристиката им пише още: инертни,
с голяма адсорбционна и проникваща активност. Едно от
най-интересните им свойства е способността им да проникват в
човешките клетки и да транспортират заедно със себе си прикачено към
тях лекарство. През последните четири години няколко американски
патента и различни статии пък показаха, че може да се използват като
радиопротектори при облъчване с неутрони или гама-радиация.
Синтезът им започва между 60-те и 80-те години на миналия век,
когато учени от различни точки на света ги създават
като част от секретна разработка
Всяка държава стига до тях по свой път, без да дава гласност на
научните си постижения. Екипите тръгват от идеята, че свободният
въглерод може да кристализира като диамант, ако е в достатъчно
количество при взривен синтез. Всъщност въглеродът има няколко
алотропни форми, графитите и диамантите са най-известните сред тях.
За пръв път нанодиамантите са синтезирани у нас през 1987 г. с
помощта на детонационни методи и взривна енергия. Патентът на
технологията принадлежи на проф. Ставри Ставрев, инженер-физик,
тогава ръководител на секция „Космическо материалознание“ към
Института по космически изследвания при БАН.
„Направих случайно първия синтез, докато готвех експеримент по
програмата на втория космонавт Александър Александров. Това беше
лабораторна сплав от волфрам и алуминий, два иначе металургически
несъвместими метала.Тъй като не можех в земни условия да повторя
експеримента в Космоса – алуминият се разтапя, волфрамът пада на
дъното, реших да търся образуване на интерметалитни фази, като
извършвам пресолването с взрив. Подготвих експеримента, но вместо
по-леко взривно вещество, използвах високоенергийна взривна смес. За
щастие такава, която съдържа свободен въглерод. Гръмна, всичко се
разпиля, но най-съвестно събрах материала от взривната камера и го
дадох за изследване на рентген. Тогава ми се обади специалист от
Института по металознание, каза, че интерметалидни фази няма, но има
стъкълца, които са много интересни. Стъкълцата се оказаха
нанодиаманти“, разказва проф. Ставрев. До момента на синтеза на
българските нанодиаманти в света липсва научно съобщение за подобно
откритие. Две години по-късно на конгрес в Красноярск българският
учен докладва за нанодиамантите, получени у нас при определени
условия. Анатолий Михайлович Ставер, професор от Техническия
университет в Красноярск, е озадачен. Той и екипът му отдавна са
синтезирали нанодиаманти, руснаците са лидери в тази област, но от
съображения за сигурност не са публикували технологията. Как
българите са успели да повторят експеримента им, без да са стъпвали
в тяхната секретна лаборатория? „Повторил съм технологията, но с
една разлика. Руските учени вграждат във взривното вещество много
чист въглерод и го превръщат в нанодиаманти. Разликата в двете
технологии е, че те работят с т.нар. мартензитен (атермичен) преход.
Аз съм взел взривно вещество на свободен въглерод. При взрива съм
докарал свободния въглерод до състояние на плазма и съм получил
монокристали, т.е. методът е дифузионно отлагане атом по атом. А те
получават поликристали. Тъй като поликристалът се състои от много
частици, той няма нужната здравина. След това започнах изследвания,
но работата ми съвпадна с периода на прехода. По онова време БАН
нямаше пари дори за парно“, връща се назад проф. Ставрев. Следва
затишие. Едва през 90-те години се появяват научни сведения за
синтезирани нанодиаманти. На този етап умните частици усилено се
създават и изучават в САЩ, в Русия, в Япония и у нас. Контролираната
доставка на лекарствата е едно от активно развиващите се направления
на съвременната медицина. С помощта на нанодиамантите като
бърза и безпогрешна транспортна система
в САЩ вече се правят опити за лечение на мозъчни тумори. Учени от
Новосибирск пък виждат в микрочастиците най-точното оръжие в битката
с туберкулозата. Бацилът на жълтата гостенка вече е резистентен към
антибиотиците и там разчитат на нанодиамантите и на два вида
полизахариди, разяснява проф. Ставрев. Изследванията показват, че
нанодиамантите може да участват с огромен успех и в най-иновативния
метод за лечение на рака - таргетната химиотерапия, насочена само
към раковите клетки. Това ще намали количеството на химиотерапевтика
десетки пъти и ще пощади от смъртната присъда милиони здрави клетки.
„През 1994-1995 г. започнах проучвания на нанодиамантите с проф.
Афродити Сивропуло от университета в Солун. Още тогава открих, че
нанодиамантите се насочват само към раковите клетки, унижожават и
всички възпалителни процеси. С проф. Анатолий Г. Коноплянников от
Центъра по клиническа радиобиология вкарахме проекта в руското
министерство на икономиката. Доклиничните и клиничните изпитания на
терапията се проведоха в Института по токсикология в Петербург.
Руснаците финансираха и финансират пълния цикъл на изследване на
продукта, а проектът се разшири и към Израел и САЩ. Всичките ми
разработки, свързани с изследвания в Русия, са обвързани с
договорености резултатите да се ползват и в България “, твърди проф.
Ставрев, който след редица скандали у нас решава да събере плодовете
на труда си вън от страната. По думите му клиничните изпитания на
кремовете му с нанодиаманти, чието производство скоро ще тръгне у
нас, също са реализирани с руски финанси. Ефектът на тази козметика
би могъл да се нарече безинжекционна мезотерапия, отбелязва проф.
Ставрев. Водени от нанодиамантите, витамините и минералите проникват
дълбоко в кожата и я регенерират. В момента в Москва текат изпитания
и на дерматологичен продукт с нанодиаманти за лечение на псориазиса.
У нас изследвания за приложението на нанодиамантите в медицината се
провеждат и в Института по физика на твърдото тяло към БАН. Там
специалистите търсят доказателства за биологичното им приложение
чрез формиране на хидроксиапатитни комплекси.
У нас се работи екипно и върху
лечението на остеопороза с нанодиаманти
Интелигентните джуджета (нано значи джудже) се синтезират във
взривна камера на специален полигон. Характеризирането на свойствата
им се извършва в институти на БАН (кристалография) и в руски
институти. В Института по молекулярна биология се пречистват и се
включват в т. нар. интелигентни гелове - полимери, които при стайна
температура са течни, но при 37 градуса по Целзий се превръщат в
желе.
„Освен нанодиаманти гелът съдържа и ендотелни прогиниторни клетки,
изолирани от кръвта на животно или на човек. Когато тези
прогениторни клетки живеят върху интелигентните гелове, съдържащи
нанодиаманти, от тях можем да създадем остеобласти – основните
клетки, които изграждат костите. Тествахме биологично полученото
композитно вещество с остеобластните клетки върху животински модели
с остеопороза в Медицинския университет в Плевен“, разяснява доц.
Маргарита Апостолова, ръководител на лаборатория към Института по
молекулярна биология. Проучването се извършва изцяло в България
върху плъхове с остеопороза. Здравината на костите на гризачите се
проследява и измерва преди и след инжектиране на гела в костта.
Експерименталните резултати в предклиничните проучвания на
остеопорозата са много добри. Оказва се, че приложени на плъхове с
чупливи кости, интелигентните полимери заедно с нанодиамантите и
клетките регенерират костта. Но добрият ефект при животните все още
не може да гарантира положителното въздействие върху хората. За
бъдат завършени предклиничните изпитания, са нужни пари, които в
последните години колабиралият фонд „Научни изследвания” към МОН не
може да подсигури. Изследванията по този проект бяха финансирани по
националната програма „Нанотехнологии” още в 2007 г.
Няма съмнение, приложението на нанодиамантите в медицината е огромно
предизвикателство пред целия свят.
Надеждите са, че покрай способностите им да пренасят лекарства или
терапевтични агенти, модифицирани под една или друга форма, те могат
да лекуват дори различни видове рак. „Един бърз преглед на научната
литература показва, че модифицираните по различен начин нанодиаманти
със или без грешки в тяхната кристална структура или с различни
закачени лекарства могат успешно да доставят лекарствата в
клетъчните култури от ракови клетки или малки животни. Преди години
учените показаха, че нанодиамантите, на които е закачена фолиева
киселина,
|

се натрупват предимно в раковите клетки на яйчниците и при
облъчване с лазер нанодиамантът поглъща много голямо количество
енергия точно заради дефектите си. Когато спре облъчването с лазер,
нанодиамантът
освобождава енергия и гори раковата тъкан
в животинския модел. Може да изгори и много малки образования, които
не може да бъде диагностицирани с високотехнологичните апарати“,
разяснява доц. Апостолова.
Изкуствено синтезираните нанодиаманти всъщност вече намират
приложение във всички сфери на индустрията и бита, надеждите на
учените са те да контролират и застрашената екологична обстановка в
света. От две години у нас в Лабораторията по екологична
биотехнология на Софийския университет с ръководител проф. Яна
Топалова съвместно с проф. Ставри Ставрев и доц. Нели Желева се
изследва способността на нанодиамантите да ускоряват и управляват
ранната фаза на пречистване на едни от най-опасните замърсители на
околната среда - фенолите и диазобагрилата. Данните за приложението
на нанодиаманти в тази сфера в световен мащаб са изключително
оскъдни. Затова и се захващат. Предварителната информация за
свойствата на нанодиамантите провокира предположението, че те биха
могли да регулират детоксикационната способност на уникални
микроорганизми – биодеграданти на рискови замърсители. Резултатите,
които са получени до момента, са обещаващи.
Колективът започва проучванията си в съответствие с две европейски
стратегии: стратегията за интелигентен, устойчив и приобщаващ растеж
„Европа 2020” и стратегията за насочване на европейската икономика
към по-интензивно и устойчиво използване на възобновяеми ресурси
„Иновации за устойчив растеж: Биоикономика за Европа“. Въпросът със
създаването на новаторска икономика, базираща се на иновации, нови
технологии и процеси на биоикономиката, е особено важен не само за
Стария континет. Пречистването и възстановяването на силно замърсени
води, седименти и активни утайки е проблем от глобален мащаб. Не
само фенолите и диазобагрилата, но и нефтените деривати,
детергентите, дървопреработващата, фармацевтичната, багрилната,
химическата промишленост замърсяват, убиват природата. Приложението
на нанодиамантите като ускоряващ и регулиращ фактор на тези процеси
е иновация. След като проучва свойствата им, екипът на Лабораторията
по екологична биотехнология допуска, че нанодиамантите могат да
увеличават ефективността и ефикасността на технологите във вече
съществуващите съоръжения. Този иновационен елемент в технологиите
би подсигурил интелигентното им управление, но и ще има огромен
икономически ефект. Ще се спестят солидни капиталовложения,
необходими за строежа на нови съоръжения.
Екипът започва работа през 2012 г. в контролирани лабораторни
условия чрез моделиране на процесите на
пречистване на замърсени води и седименти
„Започнахме изследванията си с влиянието на нанодиамантите върху
индикатори - чисти култури микроорганизми. Експериментът се оказа
многообещаващ. Идеята беше да установим какъв е ефектът на
нанодиамантите върху бактериите от рода псевдомонас, които
контролират пречиствателните процеси като цяло. Ако нанодиамантите
им въздействат, значи ще въздействат и върху скоростта и механизма
на процеса. Наистина се оказа, че нанодиамантите ускоряват началната
фаза на детоксикация, като карат клетките да синтезират по-голямо
количество и по-активни ензими, които отварят бензолния пръстен.
Микроорганизмите от род псевдомонос са сред основните фактори на
детоксикацията по две причини. Те могат да използват алтернативни
енергетични източници и така токсикантите не ги увреждат.
Алтернативният път за печелене на енергия им позволява да оцеляват в
много трудни условия при наличие на токсични вещества. Оцелявайки,
те се адаптират и първи започват да разграждат токсикантите, като
вкарват много по-бързо важни компоненти от средата директно в
клетката и така стимулират детоксикацията. Механизмите на управление
на този процес са много важни, установяването им ще ни позволи да
управляваме много широк кръг съоръжения и технологизирани екосистеми
- пречиствателни, каскади на ВЕЦ-ове, специални площадки за
замърсени почви и седименти“, разяснява проф. Топалова.
Екипът на Биологическия факултет, ангажиран с изследването, е доста
голям, по него работят и докторанти, и студенти магистри, досега са
разработени две докторски дисертации, защитени са десетки дипломни
работи. Намеренията им са през следващата година да разширят
изследванията си върху нанодиамантите и да определят токсичността им
върху микроживотни – като дафния, след това да прехвърлят
експеримента върху риби, отглеждани в аквариуми. „За нас тези два
тест обекта са много важни, защото възнамеряваме да прилагаме
нанодиамантите в технологизирани и силно замърсени хабитати,
най-вече седименти на реки, язовири, адаптивни езера. Дафниите са
храна за рибите. Ще проверим токсичността на ниво ензими, за да
видим как действат на метаболизма, на структурата им. Имаме
ихтиолози, хидробиолози, които работят с по-висшите обекти от
микроорганизмите. Нищо в околната среда няма да бъде пуснато, без да
сме сигурни, че няма да се отлага, че няма токсично действие, че
няма да увреди екосистемите. Затова всичко се моделира в затворени
лабораторни контролирани условия“, разяснява проф. Яна Топалова.
Наистина ли са безвредни нанодиамантите, след като принадлежат към
наночастиците?
На този етап в света се отделят много пари за изследване
токсичността на наночастиците. Спекулациите по темата са големи.
Твърди се или че са много опасни, или че са напълно безвредни, но
реално доказателствата сега се събират. Наночастиците са вече на
пазара - в козметичната, в хранително-вкусовата промишленост, в
електрониката и на много други места. Предлагат ни се кремове с
титаниев диоксид в наноразмери, в спрейове за почерняване на кожата.
Но все още е рано да се каже какво ще е дългогодишното им
въздействие върху човека. Американската агенция по контрол на
лекарствените средства и храните излезе наскоро с
насоки към производителите на лекарства,
медицински изделия и козметични продукти, които са в контакт с хора
и съдържат под някаква форма наночастици.
„Въглеродните нанотръбички например не са проблем, когато са в
литиевите батерии на телефона, но може да са проблем за хората,
които ги произвеждат, ако ги вдишат. За новите самолети „Еърбъс“ се
казва официално, че крилете им ще бъдат изградени с материали,
съдържащи нанотръби. Самолетът вече трябва да е направен, но
предстои да се тества. Не се знае как ще изддържа на различни
природни явления. На този етап е сигурно само, че нанодиамантите,
включени в режещи инструменти, нямат негативен ефект, защото не се
отделят от метала. Дори това да е един кухненски нож. Но като цяло
потенциалът на нанодиамантите е много голям. Още повече - те се
синтезират много лесно. Может да се получават от стари боеприпаси.
Начините за производството им са различни – може да се получават и
като покрития в среда от различна плазма. Имат огромен потенциал за
приложение и в квантовите компютри. В света съществуват няколко
огромни проекта, реализиращи се върху нанодиамантите. Американските
физици вече успяха да създадат проводник от синтетични диаманти,
който би могъл да предава квантова информация. Група български учени
също работят върху създаването на компютрите на бъдещето“, отчита
доц. Апостолова. Наноструктурите обаче навлизат толкова бързо в
живота ни, че засега е твърде рано да се каже дали са вредни, или
безопасни, отбелязва и проф. Ставрев.
Статията
се публикува със специалното разрешение на сп. Тема |